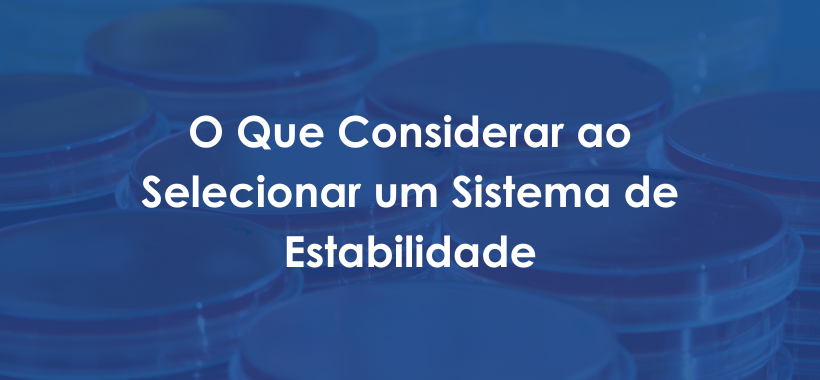

Devido aos benefícios da cannabis para a saúde, a droga já foi legalizada em muitos estados nos Estados Unidos. Entender os impactos da mudança de regulamentação nos laboratórios de análise de maconha é importante para muitas organizações. Os laboratórios devem trabalhar para se manterem no topo das melhores práticas e em conformidade com esses regulamentos.
A História da Legalização da Cannabis
O aumento das restrições ao uso da cannabis como veneno foi reconhecido pela primeira vez a partir de 1906. Enquanto a proibição da droga começou nos anos 20, em meados dos anos 30 a cannabis foi regulamentada como uma substância controlada. Por volta dessa época, 35 estados adotaram a Uniform State Narcotic Drug Act em 1937.
Com a aprovação da Lei das Substâncias Controladas (CSA) em 1970, a cannabis foi proibida tanto para uso adulto como para uso médico. Em 2012, o Colorado e Washington foram os primeiros estados a legalizar o uso adulto da cannabis.
Muitos estados aprovaram leis que legalizam o uso médico e adulto da cannabis. Até 2016, a maioria dos estados legalizou o uso da cannabis para fins médicos. A partir de 2021, dois territórios dos EUA, e D.C. juntamente com dezessete estados, legalizaram o uso adulto de maconha. Trinta e seis estados, quatro territórios dos EUA e de Washington D.C. legalizaram o uso médico.
Impactos da Regulamentação para Produtores e Laboratórios de Testes
Uma vez que o uso da cannabis para múltiplos fins foi legalizado em muitos estados, os testes regulatórios asseguram a potência da droga para garantir a segurança do consumidor. Isto significa que foram criados laboratórios com o objetivo específico de testar e certificar os produtos de cannabis.
Os órgãos regulatórios exigem que cada planta, produto e derivado de cannabis tem de ser rastreado através da cadeia de fornecimento. Isto assegura que os pacientes estão recebendo um produto legítimo e mantém os produtos ilícitos fora do mercado.
Os reguladores observaram um aumento acentuado de produtos contaminados ou uma diluição da potência. Os consumidores podem ser prejudicados com produtos contaminados. Por exemplo, os pesticidas usados durante o cultivo se comportam de maneira muito diferente quando queimados. Isso significa que as plantas de cannabis podem se tornar tóxicas. Portanto, no teste é fundamental que os resultados estejam dentro dos limites estabelecidos.
Como a Mudança da Regulamentação da Cannabis Impacta os Cultivadores e os Laboratórios de Análises
O que assola a indústria de testes de cannabis é a falta de padrões consistentes. Isso levou a práticas antiéticas com alguns produtores e laboratórios de teste de cannabis.
Práticas antiéticas
Numerosos laboratórios de teste de cannabis foram fechados por supostamente relatar resultados que não correspondem às auditorias. Alguns laboratórios destruíram evidências de dados falsificados na tentativa de impedir as investigações. Os reguladores também descobriram que alguns laboratórios de teste de cannabis estão produzindo resultados enganosos e imprecisos.
Os cultivadores de cannabis pouco éticos fazem muitas vezes fazem manobras para encontrar laboratórios de testes de cannabis que lhes forneçam resultados mais favoráveis. Você também descobrirá que esses mesmos cultivadores borrifam uma flor para aumentar o nível de potência. As flores podem ser polvilhadas com cristais de THC adicionais para aumentar os níveis de potência.
Para serem competitivos, alguns laboratórios de teste de cannabis estão preparados para falsificar resultados. Alguns irão mascarar os níveis de contaminantes em suas amostras, incluindo metais pesados e micróbios.
Riscos de testes antiéticos
Como os reguladores estão descobrindo atos de comportamento antiético nos testes de cannabis, há um efeito de fluxo. Para os produtores, milhões de dólares estão investidos em produtos de cannabis que não podem ser lançados no mercado. Se produtos contaminados forem lançados no mercado, existe um sério risco para a saúde do consumidor.
Deixar de apresentar provas de alterações durante as auditorias significa que um laboratório pode ser encerrado. Pode ser um esforço caro montar um laboratório de testes. Portanto, não faz sentido falsificar os resultados, nem faz sentido se sujeitar a ações judiciais.
Por essas razões, há uma necessidade urgente de regulamentar os padrões de conformidade em todas as áreas de análise de cannabis.
Tipos de regulamentação da Cannabis
Uma licença para permitir o teste de cannabis é concedida por local de laboratório, não de estado para estado. Um laboratório de teste de cannabis não pode ser estabelecido sem ser reconhecido pela ISO/IEC 17025. Isso não é negociável.
Requisitos de exigências estaduais significam que os laboratórios de teste de cannabis devem atender aos regulamentos estaduais. Não é apenas a padronização dos testes que é necessária. Rotulagem e terminologia, por exemplo, podem ser enganosas. Os resultados dos testes de THC podem ser definidos com base no peso seco. O problema é que os produtores têm diferentes processos de secagem e cura. Isso pode alterar os resultados.
O uso por paciente adulto é regulamentado em uma base estadual, ao contrário das diretrizes ISO. O que torna isso ainda mais complexo é que diferentes departamentos governamentais regulam as leis sobre a cannabis de estado para estado.
Como um LIMS dedicado para análise de Cannabis pode ajudar a garantir a conformidade
Tendo em vista estas complexidades e regulamentos em constante mudança, é essencial que o controle de qualidade permaneça no topo das preocupações dos gestores de laboratório.
Os regulamentos exigem que todos os produtos e derivados de cannabis sejam rastreados ao longo da cadeia de abastecimento. Os testes regulatórios garantem a potência do medicamento para garantir a segurança do consumidor. Isso garante que os pacientes estejam recebendo um produto legítimo e mantém os produtos ilícitos fora do mercado.
O que é um Laboratory Information Management System
(LIMS)?
A conformidade regulatória depende de laboratórios de teste de cannabis com um sistema de gestão de qualidade. A garantia de qualidade significa que os laboratórios de teste de cannabis precisam verificar a integridade do processo de teste. Os resultados devem ser relatados com honestidade, mesmo que uma amostra não atenda aos padrões regulatórios.
Devido ao grande volume de dados e informações, para que um laboratório de testes de cannabis se mantenha em conformidade, são necessários fluxos de trabalho robustos. Por este motivo, muitos laboratórios de testes de cannabis escolhem um sistema de gestão de informação laboratorial (LIMS) para gerir os seus fluxos de trabalho para os testes de CBD e THC.
Quais são os benefícios da utilização do LabWare GROW Cannabis LIMS?
Ter um software LIMS dedicado para análise de cannabis permite total transparência e rastreabilidade antes, durante e após o processo de teste. Um LIMS que foi desenvolvido especificamente para uso com cannabis fornece aos gerentes de laboratório um sistema robusto e automatizado necessário para manter a conformidade.
O que faz do LabWare GROW o LIMS mais procurado para laboratórios de testes de cannabis é que ele é flexível o suficiente para gerenciar diferentes requisitos de estado a estado nos EUA. Os requisitos de estado individuais já estão incorporados no seu software LIMS para cannabis. Isto significa que os laboratórios não precisam personalizar o seu LIMS de cannabis para cumprir os requisitos regulatórios.
Os custos de implementação de um LabWare Grow Cannabis são relativamente baixos. O software se integra facilmente com as plataformas externas existentes.
Permanecer em Conformidade
Os laboratórios devem fornecer provas de uma cadeia de custódia desde quando uma amostra de cannabis entra no laboratório até que o produto receba um Certificado de Análise (COA). Como um LIMS de cannabis automatiza todos os fluxos de trabalho e relatórios, o laboratório não está sujeito a erro humano. A partir do momento em que o laboratório recebe uma encomenda de um produtor, os códigos de barras QR são gerados automaticamente. Este código de barras identifica a amostra com a máxima precisão.
Automação do fluxo de trabalho
A automação com um LIMS dedicado à cannabis, como no LabWare GROW, facilita o gerenciamento de lotes e de amostras. O software LIMS para cannabis automatiza o fluxo de trabalho, o que remove erros humanos, fornecendo precisão na documentação. Estes fluxos de trabalho são compatíveis com os testes de cannabis, com todo o rastreamento necessário incorporado do início ao fim.
Como cultivador e consumidor, você pode ter certeza de que LabWare GROW lhe dará sempre resultados precisos. O software LIMS para testes de cannabis vem pré-configurado para conter fluxos de trabalho de melhores práticas que aderem aos requisitos das Boas Práticas de Laboratório (BPL) e Boas Práticas de Fabricação (BPF). Estes padrões são reconhecidos por auditores. Isto significa que um gerente de laboratório de testes de cannabis tem a tranquilidade de que ele passará em qualquer auditoria conduzida por órgãos regulatórios.
Certificado de Análise
Com um fluxo de trabalho automatizado, o software LabWare Grow Cannabis pode rastrear os fluxos de trabalho com uma precisão incrível. Isto dá ao produtor e ao consumidor a rastreabilidade desde a recepção das amostras de cannabis até ao relatório final, resultando na geração de um COA. O LabWare Grow Cannabis gere todo o ciclo de vida da amostra, desde a recepção até ao COA.
Documentação para auditorias de aprovação
Quando um laboratório que utiliza LabWare GROW é auditado, o software valida e produz relatórios de acordo como a implementação foi realizada. O gerente do laboratório pode entregar registros precisos da cadeia de custódia; desde o recebimento da amostra até o armazenamento, testes e descarte. Este processo garante o cumprimento das normas regulatórias.
LabWare GROW reduz erros de entrada de dados e agiliza o processamento de dados. Os instrumentos com interface de segurança transferem dados diretamente para o sistema. Estes registros são seguros e podem ser acessados a qualquer momento por aqueles com os níveis corretos de permissão.
Relatórios Robustos
O LabWare GROW suporta o padrão ISO/IEC 17025, gerando resultados precisos e confiáveis. Reguladores e auditores exigem registros de analistas e outras pessoas envolvidas no processo de teste. Os analistas do laboratório são obrigados a receber o treinamento adequado relativo aos procedimentos de teste de cannabis. Um LIMS de cannabis gerencia documentos, registros de treinamento de pessoal e Ação Corretiva e Ação Preventiva (CAPA) com facilidade.
Você pode reduzir o tempo gasto em relatórios para as autoridades estaduais com uma solução integrada no sistema seed-to-sale do seu estado.
Tanto cultivadores como laboratórios devem aderir às exigências regulatórias internacionais, federais e estaduais para testes de cannabis e conformidade. Não compensa tomar atalhos quando se trata de conformidade na indústria.
É imperativo investir em LIMS de cannabis de qualidade como LabWare GROW, onde todo o trabalho é feito para você. Você dormirá bem à noite sabendo que não só está em conformidade, mas que seus dados também estão seguros, protegidos e de fácil acesso em todos os momentos.